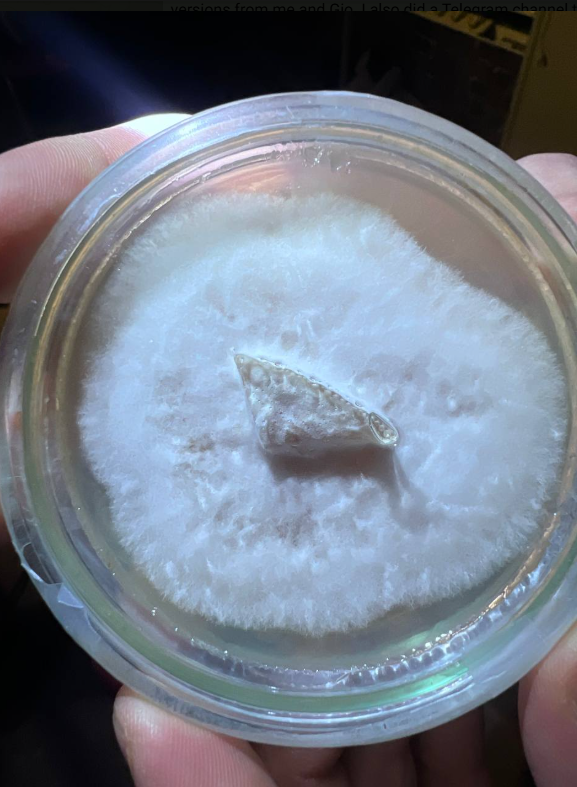

13 December 2025 · TOP Lab Berlin · Industriestraße 40 · 18:00–END
With Giorgio Alloatti, Alexandra Maciá, Xristina Sarli & Pestalotiopsis microspora
About TOP Presents
TOP Presents is TOP Lab’s monthly series, featuring community artists, researchers, and activists whose work confronts eco-social issues through hands-on experimentation.
Hosted inside TOP Lab, Berlin’s first DIY BioLab and transdisciplinary community space, the series opens conversations around regenerative cultures, more-than-human practices, and multispecies resistance.

About TOP Lab
TOP Lab is a community-run bio-art laboratory where humans, fungi, bacteria, technologies, and ideas co-evolve. Members explore living systems through intersectional environmentalism, open knowledge, skill sharing, and a DIY / DIT / DIWO epistemology — do-it-yourself, do-it-together, do-it-with-others.
Event Series: Bioglitch
Since April 2025, BioGlitch project series has been taking shape inside TOP Lab through the collaboration of Giorgio Alloatti, Alexandra Maciá, Xristina Sarli, and our invisible non-human member:
→ Pestalotiopsis microspora — the plastic-eating fungus.
BioGlitch is an evolving research and performance series (lecture performance series) investigating how fungi, data, sound, and obsolete media can form a post-capitalist, mushroom-core biopunx collective
Together, we work with a species able to metabolize one of the most harmful and “immortal” human inventions: plastic and co.
What emerges is a plot twist in the long narrative of human dominion — a mycelial insistence that even the “impossible” can be undone. Through this biopostnoise collaboration, we imagine worlds beyond speciesism, hegemony, and extractive futures.
If a fungus can rot the architecture of our waste, perhaps we can learn to rot the architectures of power too.

Program
18:00 Doors Open
19:00–20:00 — Lecture Performance
I EAT PLASTIC ITS FANTASTIC “Forming a Biopostnoise More-Than-Human Collective”

A live presentation of BioGlitch collective´s research focus:
- forming a biopostnoise, mushroom-core, biopunx group
- collaborating with Pestalotiopsis microspora and other non-human members
- experiments in decay, biosonification, data translation, and multispecies resistance
- a narrative on how fungi metabolize the materials — and metaphors — of oppressive systems
- Multispecies against speciesism
BREAK FOR DRINKS 20:00 – 20:20
20:30–21:00 — Exhibition, BioLab Tour & Interactive Installations,
TOP Lab transforms into a sonic wet-lab playground.
Instruments, incubators, and microscopes become sound devices. VHS tapes, fungal cultures, and XR realities hum back.
21:00-22:00 ACAB presents
ACAB (the human + fungal band) performs Chapter I of the BioGlitch cycle:
“I Eat Plastic, It’s Fantastic” — a feedback-loop offering to the fungus, where its genome becomes sound, becomes magnetic tape, becomes food again.

22:00–END — Sonic Decay & Closing Acts
Mizuki (DE-JP)
Mizuki Ishikawa is a Berlin-based improviser and sound artist. In her improvisations with objects and DIY electronics, she manipulates the acoustic environment of a space using everyday objects and feedback techniques, while simultaneously exploring the conditions of performance through simple gestures and ordinary activities. Through improvisation, Mizuki aims to integrate the space, the audience, herself and time into a cohesive experience.
https://mizukiishikawa8.wixsite.com/website
Bootycall (DK-FN)
freaky noise, high impulse no regret
https://kvindelig.bandcamp.com/album/bootycall-ass-of-an-angel
Vskbjorn (DK-IT)
pushing chunks of RAM to speakers and back
Gianluca Elia is a sound-artist working with hacking music technology, exploring what sonic machines can do beyond their utilitarian design. His works span from playing in the noise scene in Copenhagen, to acting as a bridge between composers and computers, to artistic/scientific research in experimental musicking and sound technology.
Attention: Bring your own earplugs.
Suggested entry donation
Performances exploring frequencies of resistance, analog rot, and more-than-human noise.
Full lineup announced in the Telegram channel.
Livestream & Virtual Exhibition
The performance will take place in the underground mushroom lab, TOP Lab Industriestrasse 40, Schaetzelbergstrasse 1-3 12099 Berlin and will also be streamed inside the digital pavilion of Prima Materia, part of The Wrong Biennale 2025–26 — a curatorial exploration of non-human and more-than-human intelligence, in collaboration with TOP.
THE WRONG IMAGE
🔗 Prima Materia Biennale
https://thewrong.org/PrimaMateria
🔗 BioGlitch installation: “Mycohacking the Future”
https://newart.city/show/mycohacking-the-future

In the BioGlitch installation, a streaming frame will appear on 13 December, broadcasting the performance live from the lab.
Join the Mushroom-Core Community
For streaming, updates, behind-the-scenes experiments, and the full event lineup:
Join the ACAB Telegram channel.
Post-capitalist futures grow in petri dishes.
Decay is a form of resistance.
Welcome to the more-than-human band.